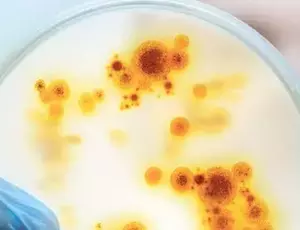
Análise microbiológica

Descubra a solução perfeita para a aplicação do seu laboratório!
Navegue pelas categorias abaixo e encontre as soluções Veolia que melhor atendem às suas necessidades.
ANÁLISE MICROBIOLÓGICA
A análise microbiológica precisa de água muito pura em todas as etapas para ter resultados exatos ao detectar microrganismos. Deve-se usar água purificada ou destilada que siga os padrões específicos, pois sua qualidade afeta o crescimento dos meios de cultura e a confiança nos resultados.
>Conheça nossas soluções de água tipo I e II+

CROMATOGRAFIA GASOSA
A qualidade da água é essencial na preparação de amostras, brancos e padrões, principalmente com amostras aquosas. Esta técnica analítica sensível, usada para separar compostos voláteis ou semivoláteis (VOCs), necessita de água pura para garantir resultados precisos e evitar interferências na análise.
>Conheça nossas soluções de água tipo I

CROMATOGRAFIA LÍQUIDA
A cromatografia líquida exige água ultrapura (Tipo 1) com resistividade >18 MΩ.cm e TOC <3 ppb, sendo a água o reagente mais usado no processo. Sua qualidade afeta todo o processo analítico, onde contaminantes podem causar problemas como picos fantasma e resultados imprecisos.
>Conheça nossas soluções de água tipo I

CULTURAS DE CÉLULA
Para culturas de células, é necessária água ultrapura apirogênica (Tipo I), enquanto culturas bacterianas aceitam água Tipo II. A água é essencial no preparo de meios e tampões, onde contaminantes podem comprometer a viabilidade celular e os resultados experimentais.
>Conheça nossas soluções de água tipo I e II+

ELETROQUÍMICA
A qualidade da água é crucial para a precisão das medições elétricas, exigindo água Tipo II para aplicações gerais e Tipo I para análises mais sensíveis. A água deve estar livre de impurezas para não interferir nos tampões de referência e nas medições de sinais elétricos minúsculos, onde contaminantes podem causar interferência de fundo.
>Conheça nossas soluções de água tipo I e II

ESPECTROFOTOMETRIA
A qualidade da água é essencial para evitar interferências nas medições, exigindo água Tipo II para aplicações gerais e água ultrapura para análises mais precisas. A água, usada no preparo de amostras, brancos e lavagem de cubas, deve estar livre de contaminantes que possam absorver ou espalhar a radiação, evitando medições incorretas.
>Conheça nossas soluções de água tipo II+

ESPECTROMETRIA DE MASSA
Essa aplicação requer água ultrapura (Tipo I) devido à sua extrema sensibilidade, com especificações rigorosas para ICP-MS (18,2 MΩ.cm, TOC <10 ppb), GC-MS (TOC <3 ppb) e LC-MS. A água ultrapura é essencial em todas as etapas analíticas, pois contaminantes podem causar problemas como picos fantasma, alteração nos tempos de retenção e perda de resolução.
>Conheça nossas soluções de água tipo I e I+

ESPECTROSCOPIA ATÔMICA
Os requisitos de água variam conforme a técnica: FAAS aceita água Tipo II, enquanto GFAAS e ICP-AES exigem água Tipo I com alta resistividade e baixo TOC. A água, usada em brancos, padrões e amostras, deve estar livre de contaminantes, especialmente em análises de ultra-traços com limites de detecção abaixo do nível de ppb.
>Conheça nossas soluções de água tipo I e II

GENÉTICA
A água ultrapura (Tipo I) é essencial para PCR, sequenciamento de DNA/RNA e eletroforese, exigindo alta resistividade, baixo TOC, ultrafiltração e ausência de nucleases. A água deve ser especialmente livre de RNases e endotoxinas, sendo crucial para garantir resultados confiáveis em todas as aplicações genéticas, incluindo pesquisas com anticorpos monoclonais.
>Conheça nossas soluções de água tipo I

HPLC
Uma técnica analítica que exige água Tipo I para aplicações gerais e Tipo I+ para análises sensíveis, com resistividade >18 MΩ.cm, TOC <2 ppb e baixa contagem bacteriana. A água, sendo o principal reagente, deve ter alta pureza para evitar degradação do desempenho cromatográfico e comprometimento dos resultados em eluentes, amostras e padrões.
>Conheça nossas soluções de água tipo I e I+

IMUNOQUÍMICA
Na imunoquímica, técnicas como imunocitoquímica exigem água ultrapura apirogênica com alta resistividade, baixo TOC e ausência de contaminantes. Água de alta pureza é fundamental para evitar depósitos duros, biofilmes bacterianos e interferências com anticorpos e ensaios, pois há contato direto com as amostras em várias etapas.
>Conheça nossas soluções de água tipo I

REQUISITOS DE ÁGUA DE LABORATÓRIO EM GERAL
Em laboratório, os requisitos de água variam: Tipo III serve para lavagem geral, banhos e autoclaves, enquanto técnicas sensíveis exigem Tipo II ou Tipo I com alta resistividade e baixo TOC. A qualidade da água afeta diretamente a eficiência e vida útil dos equipamentos, sendo crucial água ultrapura para aplicações críticas como preparação de reagentes e análise de água.
>Conheça nossas soluções de água tipo I, II e III
Continue navegando
Soluções de purificação de água de laboratório
Descubra as soluções de purificação de água ELGA para laboratórios. Desde água ultrapura Tipo I até água Tipo III, temos o sistema ideal para suas necessidades de pesquisa.
Lab Experience
Explore conteúdo especializado sobre água ultrapura, técnicas analíticas e protocolos laboratoriais. Descubra as melhores práticas em purificação e soluções personalizadas para otimizar a rotina do seu laboratório.
Fale com um especialista
Entre em contato com um de nossos especialistas, invista em soluções inteligentes de purificação de água de laboratório.





